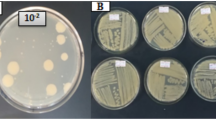

Abstract
A SUBSTANCE reacting as a hexosamine but which is not glucosamine or galactosamine has been found in 6 N hydrochloric acid hydrolysates of a variety of bacterial cell walls by Cummins and Harris1 and in peptides isolated from spores of Bacillus megatherium, B. subtilis and B. cereus by Strange and Powell2. There is evidence that in all cases the same substance is involved, and recently in this laboratory a similar compound was isolated from acid hydrolysates of cells of Micrococcus lysodeikticus in sufficient quantity for comparison with that from spore peptide, which showed that it was identical in a number of properties. The amino-sugar would therefore seem to be widely distributed in bacteria. The base has now been obtained in crystalline form from acid hydrolysates of spore peptide (Fig. 1) by the use of ion-exchange resins. Investigation of the crystalline compound has shown that it is not a simple hexosamine ; for example, after treatment with ninhydrin according to the method of Stoffyn and Jeanloz3, followed by paper chromatography, a spot was obtained which reacted with aniline phthalate4 and other sugar spray reagents like a pentose but which had an R F value considerably lower than that of arabinose, lyxose, xylose or ribose. This product reduced ammoniacal silver nitrate but did not react with naphtho-resorcinol–trichloracetic acid5.
This is a preview of subscription content, access via your institution
Access options
Subscribe to this journal
Receive 51 print issues and online access
$199.00 per year
only $3.90 per issue
Buy this article
- Purchase on SpringerLink
- Instant access to full article PDF
Prices may be subject to local taxes which are calculated during checkout
Similar content being viewed by others
References
Cummins, C. S., and Harris, H., Biochem. J., 57, xxxii (1954); J. Gen. Miorobiol., 13, iii (1955).
Strange, R. E., and Powell, J. F., Biochem. J., 58, 80 (1954).
Stoffyn, P. J., and Jeanloz, R. W., Arch. Biochim. Biophys., 52, 373 (1954).
Partridge, S. M., Nature, 164, 443 (1949).
Partridge, S. M., Biochem. J., 42, 238 (1948).
Elson, L. A., and Morgan, W. T. J., Biochem. J., 27, 1824 (1933).
Dische, Z., and Borenfreund, E., J. Biol. Chem., 184, 517 (1950).
Tracey, M. V., Biochem. J., 52, 265 (1952).
Immers, J., and Vasseur, E., Nature, 165, 898 (1950).
Author information
Authors and Affiliations
Rights and permissions
About this article
Cite this article
STRANGE, R., DARK, F. An Unidentified Amino-sugar present in Cell Walls and Spores of Various Bacteria. Nature 177, 186–188 (1956). https://doi.org/10.1038/177186a0
Issue date:
DOI: https://doi.org/10.1038/177186a0
This article is cited by
-
Adventures in viscous solutions
Molecular and Cellular Biochemistry (1974)
-
Glucosamine Values of Muramic Acid and other Amino-Sugars by the Elson and Morgan Method
Nature (1960)
-
Some Changes in the Surface Structure of Gram-Negative Bacteria Induced by Penicillin Action
Nature (1958)
-
Cell-Wall Amino-Acids and Amino-Sugars
Nature (1957)